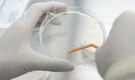
‘Disease X’ outbreak widens as UN sends health team to Congo

-
Tuberculosis killed 1.23 million last year: WHO
Deaths from TB were down three percent from 2023, while cases dropped by nearly two percent, the World Health Organization (WHO) said in its annual overview.
-

Countries reach historic WHO pandemic agreement: Report
The legally binding pact is intended to shore up the world's defences against new pathogens after the COVID-19 pandemic killed millions of people in 2020-22
-

WHO says polio mass vaccination campaign to resume in Gaza
"The current environment in Gaza, including overcrowding in shelters and severely damaged water, sanitation and hygiene infrastructure, which facilitates fecal-oral transmission, create ideal conditions for further spread of poliovirus," the WHO statement said.
-

‘Disease X’ outbreak widens as UN sends health team to Congo
Over 400 cases of the unidentified illness — marked by fever, headache, cough, runny nose, and body aches — have been reported since late October
-

What is Clade 1b strain? Know all about deadlier version of mpox virus – 5 points
Clade 1b strain of the mpox virus was first identified in the eastern region of Democratic Republic of Congo.
-

India sounds alarm amid global mpox surge: Airports, borders, hospitals on alert - Top 5 updates
Mpox latest news; According to the official guidelines issued by the health ministry, three Delhi hospitals have been designated as the nodal centres.
-

World Mental Health Day: History, significance and theme for 2023
World Mental Health Day is observed every year on October 10 to raise awareness about mental health and well-being.
-

WHO, Ayush ministry to hold first global summit on traditional medicine
According to the ministry, the summit will take into account the vast experience and expertise of the country in traditional medicine
-

Explainer: How the World Health Organization could fight future pandemics
A new pact is a priority for WHO chief Tedros Adhanom Ghebreyesus who called it a "generational commitment that we will not go back to the old cycle of panic and neglect" at the U.N. agency's annual assembly.
-

WHO warns against using artificial sweeteners
Data by the World Health Organisation suggests that high intake of non-sugar sweeteners has been linked to obesity, which affects nearly 40 percent of the global adult population and millions of children
-

COVID-19 no longer a global health emergency: WHO
WHO chief Tedros Adhanom Ghebreyesus has also warned of the ongoing impact of Long Covid, which provokes a long line of often severe and debilitating symptoms that can drag on for months or years.
-

Huge biological risk' after Sudan fighters occupy lab: WHO
"There is a huge biological risk associated with the occupation of the central public health lab... by one of the fighting parties," Nima Saeed Abid, the WHO's representative in Sudan, said.
-

IndiGo shares videos of pilot, crew working out on World Health Day
IndiGo shared videos of its pilots, cabin crew and ground staff members working out on World Health Day 2023.
-

WHO sending medics and supplies to Turkey and Syria earthquake zone
It will send a high-level delegation to coordinate its response as well as three flights with medical supplies, one of which is already on its way to Istanbul, WHO Director-General Tedros Adhanom Ghebreyesus said.
-

Gambian cough syrup deaths: Health ministry forms four member panel
The committee will also advise and recommend DCGI about further course of action.
-

'We're still in the tunnel': WHO chief says pandemic not over
He stressed, "it is still a long way off, and the tunnel is still dark, with many obstacles that could trip us up if we don't take care."
-

New COVID-19 cases, deaths keep falling nearly everywhere: WHO
The World Health Organization (WHO) said COVID-19 infections dropped everywhere in the world while deaths decreased everywhere except for Southeast Asia, where they climbed by 15 percent, and in the Western Pacific, where they rose by 3 percent.
-

Can Monkeypox patients remain asymptomatic like COVID, ICMR plans sero-survey to assess
India has so far reported 10 cases of monkeypox and one fatality from the infection.
-

ICMR-NIV analysis finds A.2 strain of monkeypox virus in first two cases
The A.2 strain, which was detected in the US last year, has not been linked to major clusters. The current outbreak is being driven by the B.1 strain of monkeypox virus, Dr Pragya Yadav, a senior scientist at the National Institute of Virology (NIV) and lead author of the study, said.
-

Monkeypox: Jharkhand govt asks officials to remain on alert, keep isolation beds ready
The samples of the girl have been collected and would be sent to the National Institute of Virology (NIV), Pune for testing, he said.
-

Monkeypox emergency could last months, with window closing to stop spread, experts say
WHO Europe has forecast just over 27,000 monkeypox cases in 88 countries by Aug. 2, up from 17,800 cases in nearly 70 countries at the latest count.
-

Monkeypox has likely spread undetected 'for some time,' says WHO
"The sudden appearance of monkeypox in many countries at the same time suggests there may have been undetected transmission for some time,": World Health Organization
-

WHO calls emergency meeting as monkeypox cases cross 100 in Europe
Many of the cases are not linked to travel to the continent. As a result, the cause of this outbreak is unclear, although health authorities have said that there is potentially some degree of community spread.
-

WHO estimates 4.74 mn COVID-19 deaths in India in 2020, 2021; nearly 10 times the official toll
As per the UN body, there were 14.9 mn excess deaths associated with COVID-19 by end-2021. The official count of deaths directly attributable to COVID-19 and reported to WHO in that period -- from January 2020 to the end of December 2021 -- is slightly more than 5.4 million. This means that the estimated toll is 9.5 million higher than the recorded fatalities.
-

World Health Day 2022: WHO picks 'Our Planet, Our Health' as theme
World Health Day 2022: The choice of this theme has been driven by the coronavirus pandemic, pollution and an increasing incidence of diseases, WHO said.